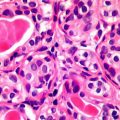
Bağışıklık sisteminin yeni keşfedilen özelliği ‘tüm kanserleri tedavi edebilir’

Murat Altaş
Kedi kakası parazitinin vücudumuzda gizlenmesine yardımcı olan gen
Dünya nüfusunun yaklaşık dörtte biri, aktif hale geldiğinde körlüğe ve hatta ölüme neden olabilen Toxoplasma gondii parazitini taşıyor. MIT'den araştırmacılar, kedi kakası ve az pişmiş yiyeceklerden y...
Kendini yenileyebilen “canlı beton” geliştirildi
ABD'deki Kolorado Üniversitesi'nden bilim insanları, kendi kendine büyüyebilen ve kendisini yenileyebilen bir “canlı beton” üretti. Jelatin, kum ve fotosentetik bakterilerin karışımından meydana gelen...
Yangınlar gezegeni, yangınlar kıtaları, kavrulan 1 milyar canlı, hey nereye gidiyoruz?
Bu aklımızın bilgi ve düşünce boyutlarını aşan yeni bir durum. Dünyada yangınların eksik olmadığını biliyoruz. Aslında yangınlar yerkürenin orman ve bitki örtüsü için oldukça doğal. Özellikle çok sıca...
HBT Dergi 199. Sayı – 17 Ocak 2020
Artık erken ilkbahar, susuz yaz.. Ve kıtasal yangın! Kanal İstanbul ve İstanbul - Doğan Kuban "Büyük bir" ve insan - Tanol Türkoğlu Solucanlar ve Kanal İstanbul - Müfit Akyos Rüzgar ve Güneş enerjiler...
SSM’de Vasıf Kortun Konferansı
Güncel sanat, sanat kurumları ve sergi pratikleri konularında çalışan küratör, eğitmen, yazar Vasıf Kortun, Sakıp Sabancı Müzesi (SSM)'nde, 17 Ocak Cuma günü saat 14.00’da “Anıt ve Belge, Eser ve Arşi...